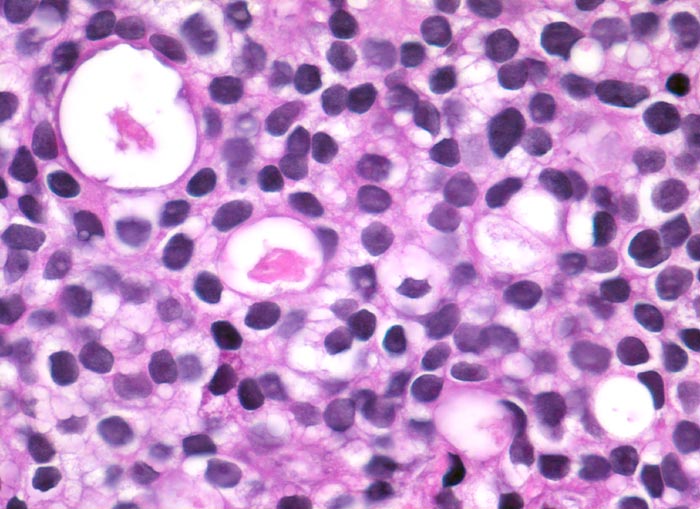

PathoPic – image database / PathoPic ID 3404 - Prostatakarzinom
de
Diagnose
Prostatakarzinom
Diagnose Gruppe
maligner Tumor
Topographie
Prostata
Topographie Gruppe
Genitalorgane, männlich
Beschreibung
Monomorpher kribriformer Tumor bestehend aus kleinen Tumorzellen mit rundlichen Kernen mit promimenten Nukleolen.
Klinik
St.n. Bestrahlung eines Prostatakarzinoms. Jetzt Tumor in der Harnblasenwand.
Bilder Typ
Histologie
Vergrösserung
400
Alter
64
Geschlecht
männlich
Datum
Ersteintrag: 22.12.2002
Update: 30.07.2010